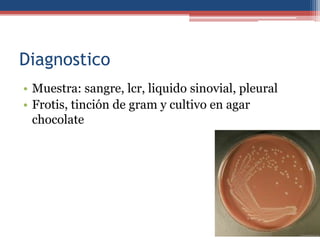
Diagnostico
• Muestra: sangre, lcr, liquido sinovial, pleural
• Frotis, tinción de gram y cultivo en agar
chocolate

Este documento describe la bacteria Haemophilus influenzae, incluyendo su ecología, epidemiología, factores de virulencia, causas de meningitis y su tratamiento. H. influenzae es una bacteria gram-negativa, aerobia o facultativa, que requiere factores nutricionales específicos. Se divide en cepas encapsuladas y no encapsuladas, y la transmisión ocurre por contacto directo o inhalación. La meningitis es causada comúnmente por la cepa serotipo b e incluye síntomas como fiebre, dolor de cabeza y n